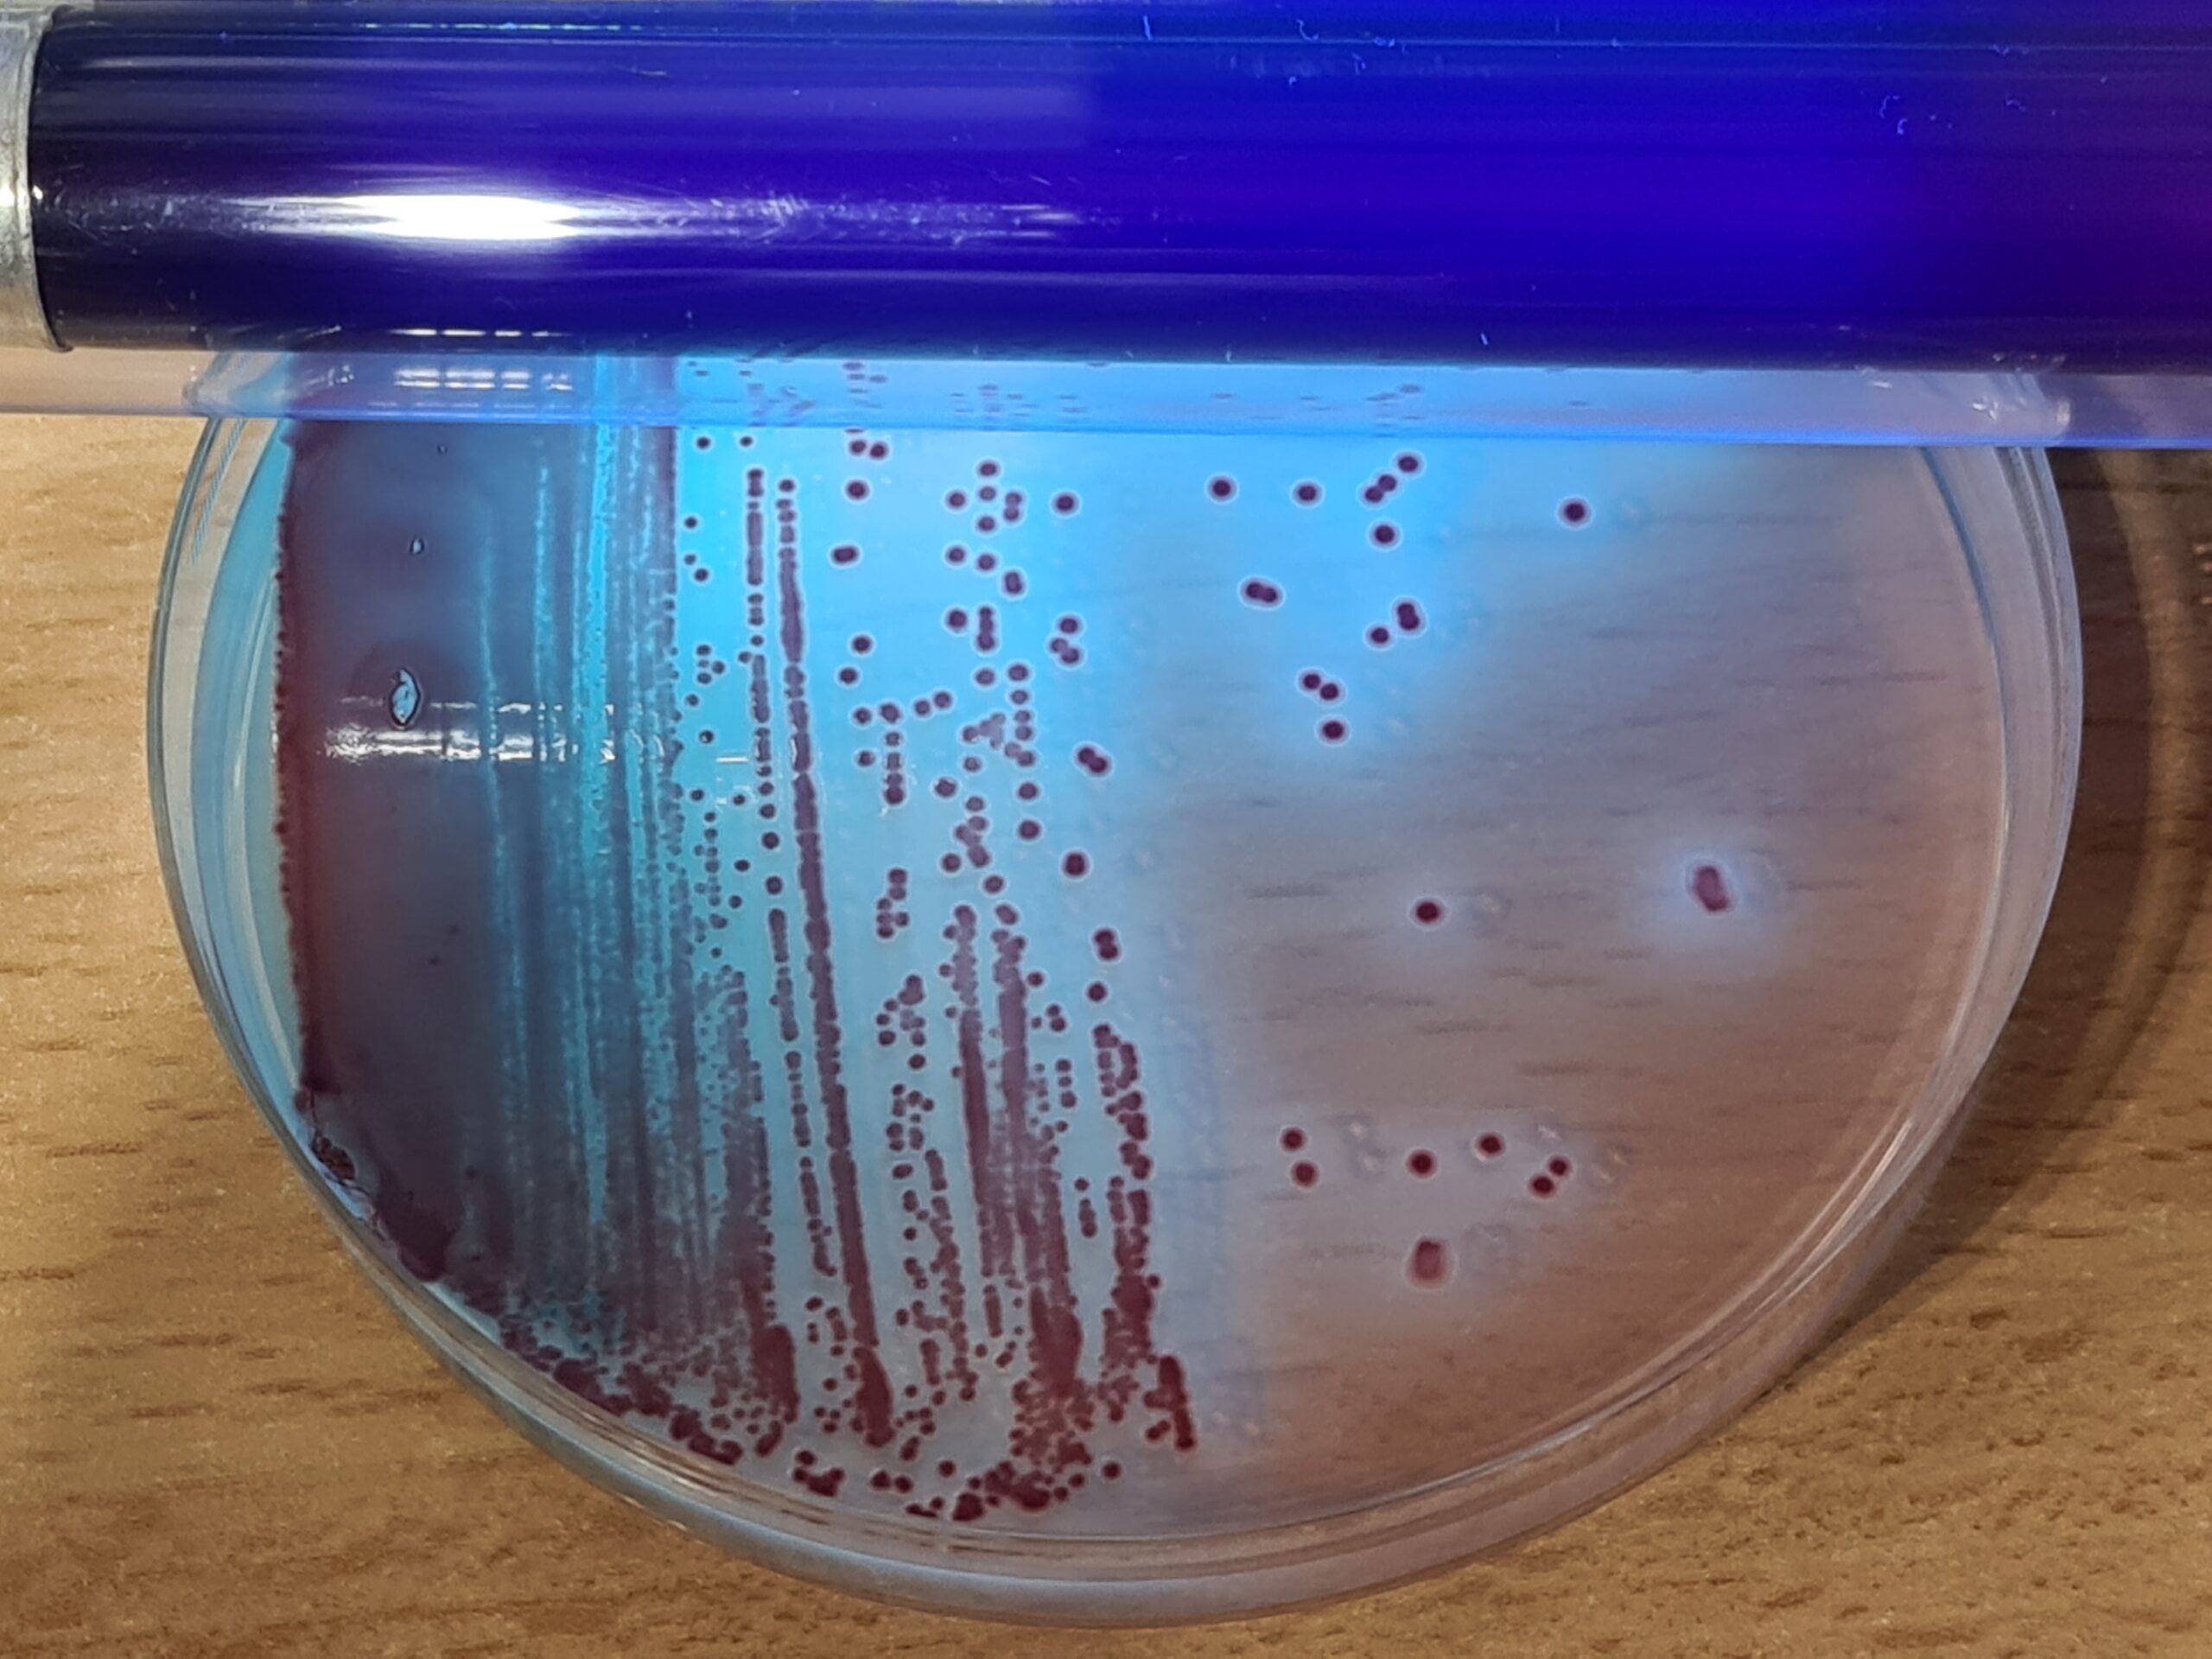
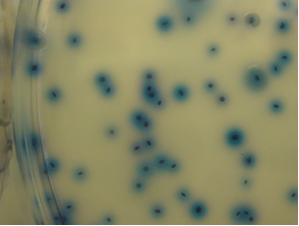

Agua de uso cosmético, la gran olvidada por casi todos. Parámetros que analizar, muestra mínima y métodos que evitan falsos negativos
LAS MONOGRAFÍAS DE MICROKIT. Tema 15
MONOGRAFÍA Agua de uso cosmético, la gran olvidada por casi todos
1-Situación legislativa de las aguas de uso cosmético
La legislación se ha olvidado de este tipo de aguas, tan importante para la industria cosmética por ser la materia prima de mayor impacto en sus fabricados.
La legislación UE
Directiva Europea 2015/1787 de 6/X) y por ende la española (Real Decreto 902/2018 de 20/7) sobre aguas de consumo humano, añadió a las aguas de la salida de las potabilizadoras: los grifos públicos y las aguas de la industria alimentaria;
pero “se olvidó” de los grifos privados y de las aguas de uso cosmético.
Aún así, dicha legislación se centra en los indicadores de infiltración de aguas residuales (E.coli-Coliformes y Enterocos fecales) y naturales (Clostridium perfringens y sus esporas) y en dos indicadores de higiene (recuento de aerobios a 22ºC y a 35ºC en YEA) y, al aplicarla a las aguas envasadas y hospitales, añade Pseudomonas aeruginosa.
Pero no tiene en cuenta otros patógenos que suelen formar biofilms y acumularse en el interior de las fábricas de cosméticos.
Muchos laboratorios, por desconocimiento, están asimilando las aguas de uso cosmético a esta legislación, olvidándose de los parámetros más problemáticos que proceden de su agua y generan las más frecuentes retiradas de mercado de producto final.
Otros se limitan a hacer un recuento de aerobios en R2A a 35ºC como si se tratase de aguas purificadas de uso farmacéutico (siendo esto realmente cierto sólo en las fábricas de medicamentos que además fabrican cosméticos y en alguna fábrica excepcional de cosméticos).
Muestra mínima
Además, muchos laboratorios olvidan que los microorganismos del agua se deben buscar en muestras mínimas de 100 mL, no en 1 mL (excepto los aerobios), y analizan el agua como si fuese una materia prima más, con los mismos parámetros y medios que los cosméticos, en 1 mL de agua, lo cual resulta de dudosa utilidad.
Por otra parte, muchas fábricas de cosméticos no tienen acceso a aguas de red que tratar o que purificar y, o bien la tratan o “purifican” a partir de aguas de pozos, o bien la compran a proveedores de aguas de usos químicos que no analizan los parámetros microbiológicos adecuados
y por tanto pueden ser una fuente de contaminación microbiana de la fábrica y de sus fabricados.
Si no lo son, en muchos casos, es gracias al buen trabajo de la sinergia conservante de sus productos finales, pero eso no es seguir GMPs (BPLs, ISO 22716).
Ya que así los microorganismos no aparecen en los cosméticos, no porque no vengan del agua contaminada, sino porque los conservantes los eliminan, pero dejando sus células y sus toxinas.
2-Parámetros que, a nuestro criterio, deberían controlarse en las aguas de uso cosmético
1-El recuento de aerobios a 22ºC
durante 3-5 días en YEA que se analiza en 1 mL en las aguas de consumo humano, es indicador del estado de higiene general, por mantenimiento dentro de límites adecuados de la población de aerobios saprófitos
2-El recuento de aerobios a 35ºC
durante 2 días en R2A que se analiza en 1 mL en las aguas farmacéuticas, es indicador del estado de higiene general, de la población de microorganismos aerobios asociados al hombre (por su temperatura óptima de crecimiento).
La mayor parte de esta población no se detecta a 22ºC y la mayor parte de la población a 22ºC no se detecta a 35ºC, por lo que toda industria cosmética debería realizar ambos recuentos.
3-La búsqueda de E.coli y demás coliformes
en 100 mL de agua de consumo humano, permite detectar infiltraciones de aguas residuales en la red de aguas potables y fábricas de alimentos, que son accidentes recientes (menos de 24h en el caso de E.coli, ya que no se trata de una bacteria del agua, sino intestinal, y en el agua no es viable mucho más tiempo).
Toda industria cosmética debería analizar sistemáticamente que el agua de la que proviene su agua tratada o purificada no contiene estos dos indicadores de contaminación fecal, ya que cualquier fallo las hará penetrar en su fábrica.
Da igual que haya 1 ufc/100 mL que 100.000 ufc/100 mL, ya que una vez entre una sola célula, se multiplicará en la red interna y tarde o temprano acabará infectando el producto final.
Por ello, no debemos someternos al análisis de filtración de membrana, que por ser un método destructivo, provoca un 21% de resultados falsamente negativos (aguas que los contienen y no son detectados) en E.coli y demás coliformes (JACOBS & Co., Mayo/1986, App.Env.Microbiol., Vol. 51, nº 5, pp.1007-1012, confirmado en 18 años de intercomparación Seilagua).
Por eso la versión más moderna de la ISO 9308 (la obligada en aguas de consumo humano) permite cambiar la MF en MugPlus (CCA), por el método NMP con caldos cromo-fluorogénicos.
En aguas cosméticas, que no están sometidas a esa ISO, ni por tanto a recuentos, podemos usar esos mismos caldos cromo-fluorogénicos con el método P/A y evitar la parafernalia que supone el recuento NMP, ahorrándonos estar todos los días contando ceros y pudiendo limitarnos así a observar si no hay crecimientos, como debe ser.
4-La búsqueda de Enterococos fecales
en 100 mL de aguas de consumo humano, es una ampliación del indicador E.coli-coliformes de la misma problemática, a contaminaciones de aguas fecales más lejanas en el tiempo, ya que estos microorganismos, del mismo origen intestinal, aguantan perfectamente viables 2 semanas en el agua;
además amplía la búsqueda de contaminantes a infiltraciones fecales animales, no solo humanas, que son de la misma importancia.
En aguas de uso cosmético que ya han sido analizadas afuera de nuestra fábrica como aguas de consumo humano, podemos elegir cualquiera de los dos parámetros (E.coli-Coliformes o Enterococos fecales) ya que hasta podría ser redundante analizar ambos.
Pero uno de ellos sí es necesario analizarlo, para comprobar que desde la potabilizadora donde se analizó el agua que nos llega, hasta nuestra fábrica, no ha habido infiltración de aguas residuales, sobre todo si hay obras, lluvias copiosas o inundaciones entre ambas instalaciones.
La elección habitual es E.coli-Coliformes, ya que pocos laboratorios analizan los enterococos fecales en su producto final (aunque también deben estar exentos para demostrar la inocuidad que exige la legislación cosmética).
De hecho, gran parte de las Klebsiella, Enterobacter, Pluralibacter, Citrobacter… que encontramos en producto final como alterativos e incluso como patógenos, proceden del agua.
5-La búsqueda de Clostridium perfringens
y sus esporas en 100 mL de agua de consumo humano, no se hace como búsqueda del patógeno en sí…
…sino como búsqueda de un indicador de infiltración de aguas naturales en la planta potabilizadora (por ejemplo una lluvia que desborde por encima del nivel del agua de la planta y la contamine con el agua de los torrentes y charcos, o un fallo en el sistema de filtración de arena-carbón del agua bruta inicial).
Ello puede llevar a infiltración de Enterovirus y Protozoos (Cryptosporidium, Giardia, Entamoeba…) a la red de aguas de consumo humano, de ahí la importancia extrema de este parámetro en aguas potables;
pero no parece tan importante su búsqueda en aguas de uso cosmético, como sí lo son los otros dos parámetros que no se buscan en las aguas de consumo humano:
6 y 7- Para seguir GMPs,
aunque en cosmética sean menos explícitas que en medicamentos, se debe buscar Pseudomonas aeruginosa y Burkholderia cepacia en aguas de uso cosmético, ya que aparecen con suma frecuencia en muchas fábricas donde se buscan por primera vez.
Ambas forman biofilms protectores de sus microcolonias; las formas planctónicas que detectamos en los análisis en los que buscamos activamente estos microorganismos, son sólo sus “células de expansión” (con misión similar a las esporas de otros microorganismos)…
…que escapan de la matriz para invadir más y más superficies sumergidas, de modo que cuando se detectan en el agua, es porque la fábrica ya ha sido infectada.
Recuentos de 10-20 ufc/100 mL de P.aeruginosa y/o de B.cepacia son frecuentes en aguas que no han sufrido más control que un “recuento total con resultados excelentes”, ya que la filtración de membrana (MF) para su detección estresa y dificulta la manifestación de estos dos microorganismos a niveles sorprendentes:
hasta un 33% de las aguas que contienen estos patógenos no son detectadas por MF, dando falsos negativos para ambos.
De ahí la importancia de emplear métodos no destructivos, como los infalibles caldos Presencia/Ausencia que ha desarrollado y validado intercomparativamente Microkit en las 3 ultimas décadas, con resultados inmejorables.
3-Los métodos que mejoran la rapidez de los resultados y la robustez del análisis
El recuento de aerobios en 1 mL,
tanto si después se incuba a 22ºC como si se hace a 35ºC, debe hacerse por siembra en masa.
Microkit inventó hace ya más de una década las DryPlates-TC Water con YEA (medio ISO) para el recuento a 22ºC y las DryPlates-R2A (medio Farmacopea) para el recuento a 35ºC…
…ambas son placas preparadas de medio deshidratado que permiten la siembra en masa directa de 1 ml de agua sin tener que estar fundiendo y enfriando agares.
Dado que no hay legislación específica ni ortodoxia legislativa en aguas de uso cosmético, nadie nos obliga a emplear un medio concreto, y ambos sirven para la siembra de aerobios oligotrofos a ambas temperaturas, por lo que podemos elegir el que más nos guste.
La búsqueda de E.coli y demás Coliformes
en 100 mL puede hacerse con el método Presencia/Ausencia para ahorrarnos el 21% de falsos negativos que proporciona el método de filtración de membrana…
…y para ahorrarnos la parafernalia de tubos múltiples o de cubetas especiales que precisa el método NMP.
A fin de cuentas nos da igual cuántos E.coli/coliformes haya en el agua, dado que no debe haber ni una sola célula…
…que indicaría una infiltración de aguas residuales y la imposibilidad de emplear esa agua en producción hasta tratarla adecuadamente y verificar que el problema ha desaparecido.
El problema de buscar Pseudomonas aeruginosa
en aguas, por Filtración de membrana, es que se destruyen numerosas células durante la filtración y se obtiene nada menos que un 33% de muestras con resultado falsamente negativo (datos de 18 años de intercomparación Seilagua).
Microkit creó hace ya casi 3 décadas el Pseudocult P/A, un caldo cromogénico selectivo que, añadido a 100-250 ml de muestra de agua, genera color rosado-rojo en 24-72h y fluorescencia en presencia de Pseudomonas aeruginosa.
La validación que demostró el 33% de falsos negativos por filtración fué precisamente frente al Pseudocult, que detectó el 100% de positivos reales.
Para los usuarios que verifican varias muestras de agua cada día, MICROKIT ha diseñado este caldo cromogénico en un formato que cuesta sólo 1 €/test: los botes de polvo estéril con cucharilla dosificadora.
Lógicamente todo presunto positivo en Pseudocult se debe confirmar estriando en Agar Cetrimida y siguiendo las confirmaciones aquí indicadas.
Pero los presuntos negativos, son confirmativamente negativos, no hay que hacer nada más.
Y como la mayoría de muestras dará negativo, el trabajo se reduce significativamente. A pesar de aumentarse la eficacia.
Otro problema del método clásico por filtración (y de la confirmación de los Pseudocult virados, por estría en Agar Cetrimida) es que este agar suele tardar 48 h en permitir ver las colonias de P.aeruginosa.
MICROKIT resolvió este problema en 2013 durante el diseño de las Dryplates-PS, mediante la adición al Agar Cetrimida, del mismo cromógeno del Pseudocult P/A, lo que permite visualizar muy bien las colonias desde las primeras 18 h de incubación.
Con un inconfundible color rojo.
Para los forofos de la MF
Después diseñó este mismo medio en formato deshidratado, con el nombre Cromokit Rapid Pseudomonas Cetrimide Agar.
En dos versiones: Farmacopea «Cetrimide» para cosméticos y ISO «Cetrimida CN» para aguas.
La confirmación de P.aeruginosa
en Agar Cetrimida o en Rapid Pseudomonas Agar es muy sencilla:
basta con hacerles a las colonias recidas en 18-24h, la prueba de la citocromo-oxidasa, que debe ser positiva, ya que son aerobios estrictos.
Las tiras oxidasa de MICROKIT están estabilizadas y no se ponen azules con el oxígeno del aire.
Otra prueba más específica es la Acetamida-Nessler, positiva (pardo) para P.aeruginosa. MICROKIT la ofrece en tubos preparados y en deshidratado.
Además, las colonias de P.aeruginosa en Cetrimida y Rapid-Ps son fluorescentes (las cepas que no lo son, sí desarrollan fluorescencia en Agar King B)
Las tres pruebas se pueden conseguir juntas en el kit M-Ident-P.aeruginosa de MICROKIT.
Otra prueba adicional es la del King A (producción de piocianina típica de P.aeruginosa)
Ocasionalmente en Agar Cetrimida (o en Rapid Pseudomonas Agar) pueden crecer curiosamente algunos Gram positivos (ej: Bacillus spp, Enterococcus spp, Staphylococcus spp), generando confusión;
el primer paso para descartar falsos positivos debe ser la inmediata prueba del Neogram directa en las colonias, descartando las que no filamentan, ya que P. aeruginosa es Gram negativo y por tanto filamenta.
Con la metodología para encontrar Burkholderia cepacia
sucede exactamente lo mismo que con Pseudomonas aeruginosa:
la filtración impide la detección de numerosas muestras que son realmente positivas.
Para colmo, dada la versatilidad genética de ambas cepas y su consecuente capacidad para “comer lo que sea”, muchas cepas de Burkholderia cepacia se detectan en los kits P/A de Pseudomonas aeruginosa y muchas cepas de Pseudomonas aeruginosa se detectan en los kits de Burkholderia cepacia
(lo mismo que sucede en las placas para producto final de cosmética), de modo que a veces la contaminación que parece doble, es de una sola de las dos cepas, capaz de crecer en ambos medios (aunque en algunas ocasiones una de ellas sólo crece en el medio que no le corresponde), y otras veces ambas están realmente presentes.
Una vez crecen es fácil distinguirlas, ya que Pseudomonas aeruginosa es fluorescente (emite luz azul o amarilla en la oscuridad cuando se observa con la linterna de 366 nm) en Pseudocult y en su estría en Agar Cetrimida o Rapid Pseudomonas, pero Burkholderia cepacia no lo es.
En el kit Burkholderia P/A no se observa la fluorescencia de Pseudomonas aeruginosa porque el caldo queda opaco y así no es posible ver la fluorescencia por “fenómeno quenching” de absorción de luz.
En Rapid Pseudomonas Agar sí se ve la fluorescencia intensa azul celeste alrededor de las colonias rojas de P.aeruginosa.

Ante cualquier viraje positivo en cualquiera de los dos kits P/A, hay que estriar en ambas placas (Cetrimida y BCPT/ BCSA) para aislar colonias e identificarlas.
Normalmente el kit P/A de Burkholderia vira más rápido (18 h) que el de Pseudomonas (48 h), sea cual sea el microorganismo que lo hace virar (Burkholderia o Pseudomonas).
Tambien aquí disponemos del caldo P/A B.cepacia en polvo estéril con cucharilla.
Como siempre, todo kit positivo se confirma
estriando en BCPT Agar ó BCSA (y en este caso, mejor también en Cetrimida o Rapid Pseudomonas).
La identificación de colonias de Burkholderia cepacia debe hacerse con Neogram, Tiras estables de oxidasa y el kit M-Ident-B.cepacia
o incluso con galerías Enterotube, que a pesar de estar diseñadas para enterobacterias, su base de datos incluye algunos no fermentadores como B.cepacia, a menudo con excelentes e inequívocos resultados.
MICROKIT ofrece además el unico intercomparativo específico de aguas de uso cosmético: Seilaguas-cosméticas, con una única ronda al año (a mediados de Abril)
Si desea esta monografía completa en pdf, con las fotos que aqui no aparecen, solicítela en consultastecnicas@microkit.es
https://www.microkit.es/fichas/YEA-NUTRIENT-AGAR-CROMOGENICO.pdf
https://www.microkit.es/fichas/R2-MEDIUM-OLIGOTROFIC-AGAR.pdf
https://www.microkit.es/fichas/CROMOKIT-R2-AGAR.pdf
https://www.microkit.es/fichas/Dry-Plates-TC-R2-Prospecto.pdf
https://www.microkit.es/pdf/COSMETIKIT-Water.pdf
https://www.microkit.es/fichas/P-A-PSEUDOCULT-UE2-2019.PDF
https://www.microkit.es/fichas/P-A-PSEUDOCULT-BOTE-100g-esteril.pdf
https://www.microkit.es/fichas/P-A-BURKHOLDERIA-CEPACIA-UE-2-2019.PDF
https://www.microkit.es/pdf/KITS-PA-BOTES-100g-ESTERILES-CON-CUCHARITA.pdf
https://www.microkit.es/fichas/MPN-RACK.PDF
https://www.microkit.es/fichas/BURKHOLDERIA-CEPACIA-BCPT-AgarBase.pdf
https://www.microkit.es/fichas/CETRIMIDE-AGAR.pdf
https://www.microkit.es/fichas/CROMOKIT-BURKHOLDERIA-Agar.pdf
https://www.microkit.es/fichas/CROMOKIT-RAPID-CN-PSEUDOMONAS-AGAR.pdf
No se pierda nuestro vídeo de los viales P/A:
https://youtu.be/6OfsD7zU_8U